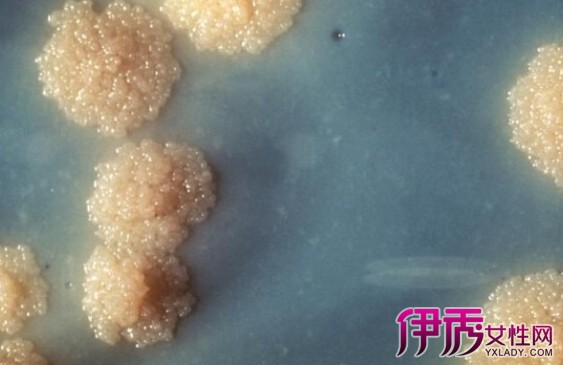
梅毒口腔症状|life.yxlady.com

梅毒的临床表现:患者常在感染后1~13周出现症状,平均3~4周。感染病原体后,一般经过以下几期:一期梅毒、二期梅毒、潜伏期梅毒以及三期梅毒。感染可以持续很多年,偶引

梅毒是什么病,有哪些症状
484x300 - 15KB - JPEG

隐性梅毒的病因
500x311 - 74KB - JPEG

【梅毒的早期症状图片】梅毒的症状是什么样的图片_亲亲宝贝网
450x290 - 316KB - PNG

地方性梅毒
300x102 - 6KB - JPEG

性病梅毒的主要症状有哪些_寻医问药网
389x285 - 120KB - JPEG

什么是“隐性梅毒”?-搜狐健康
384x649 - 57KB - JPEG

梅毒
265x300 - 9KB - JPEG

【女性感染梅毒症状】【图】了解女性感染梅毒
420x400 - 34KB - JPEG

梅毒症状
300x273 - 16KB - JPEG

【梅毒症状】【图】梅毒症状图片 男性梅毒症
550x400 - 52KB - JPEG

【感染梅毒有什么症状】【图】感染梅毒有什么
500x343 - 39KB - JPEG
梅毒口腔症状|life.yxlady.com
563x365 - 39KB - JPEG

梅毒
300x263 - 14KB - JPEG

成都男科专家解答:二期梅毒症状图片是什么样
398x284 - 19KB - JPEG

【梅毒的早期症状图片】【图】梅毒的早期症状
400x400 - 30KB - JPEG